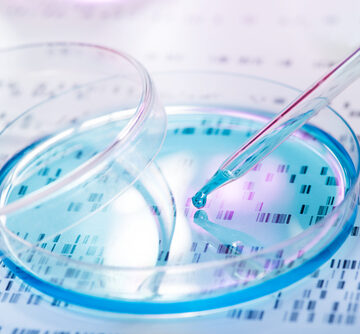
A FIRST: STEM CELLS CURE HEART DEFECT

In 2022, the U.S. Internal Revenue Service focused its audits on low-income individuals, according to IRS data analyzed by Syracuse University’s Transactional Access Records Clearinghouse (TRAC).
Tag: jan 10 2023
HOME PRICE RATE OF INCREASE CONTINUES TO SLOW
For the first time since November 2020, the rate of growth in home prices fell into single digits in October, slowing to 9.2 percent from a 10.7-percent pace in September, according to the S&P CoreLogic Case Shiller U.S. home price index.
U.S. ADDS 223,000 JOBS IN DECEMBER, MOST ARE PART-TIME
The U.S. economy filled 233,000 more jobs last month, dropping the unemployment rate from 3.6 percent to a 53-year low of 3.5 percent.
INFLATION HITTING MIDDLE CLASS HARDEST
The U.S. middle class lost 2.9 percent of its purchasing power in 2021, while lower-income households saw theirs rise 1.5 percent, according to a study by the Congressional Budget Office (CBO).
UPDATE: TWITTER FILES AND MISSOURI VS. BIDEN HELP SPUR NEW “CHURCH COMMITTEE”
Bombshells concerning Biden administration and intelligence agency illegal operations to censor free speech and political rights of Americans have now cemented action by the new Republican Congress.
TOP TREND 2023, AI WILL OWN YOU: NYT TIMES PUSHES FOR AI TEACHERS
That wonderful, life-changing role model and mentor you remember from your school days?
TOP TREND 2023, MIDDLE EAST MELTDOWN: SAUDI & U.S. VS. IRAN
The one constant that unites the U.S. and its allies is war, thus the improved relationship as of late between Washington and Riyadh.
CRYPTO-POWERED FINTECH GETS A BOOST AT NCUA
The National Credit Union Administration (NCUA) has signaled greater integration of crypto financial tech innovations with the creation of several positions.
A FIRST: STEM CELLS CURE HEART DEFECT
A new trial has again proven stem cells’ power to dramatically alter human health.
TAPPING OCEAN WATER FOR HUMAN CONSUMPTION IN A DRIED-UP WORLD
Water, water everywhere: 70 percent of the Earth’s surface is covered in water but humans can’t drink it or water their crops with ocean brine.